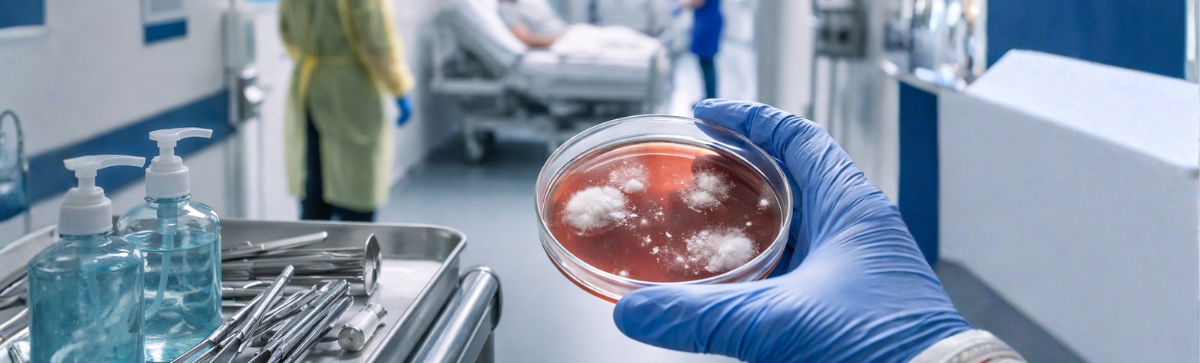
Image

A recent study was performed after 2 patients with confirmed COVID-19 were discharged from one hospital in China only to redevelop symptoms later and have a positive test for COVID-19. Researchers decided to collect nasopharyngeal and anal swabs from 58 other patients who had been hospitalized for COVID-19 and discharged before February 27, 2020. All patients were treated in Loudi, China, the median age was 46.5 years and 43.3% were women.
16.7% of participants had a positive RT-PCR test for SARS-CoV-2, including 8.3% with a positive nasopharyngeal swab and 10% with a positive anal swab. One patient had positive testing in both samples. No patient with a positive retest for COVID-19 had symptoms except for the first 2 patients who had an occasional cough.
The average time between the onset of initial symptoms and a positive retest was >1 month. The average time between hospital discharge and a positive retest was >1 week. One patient had a positive retest 56 days after the onset of symptoms. Positive retest cases were generally thought to result from persistent viral shedding versus reinfection.
In a study performed in South Korea, patients who had been released from isolation after infection with COVID-19, 25.9% to 48.9% had persistent positive testing for SARS-CoV-2. Researchers investigated 285 cases with repeat positive tests and found 790 contacts of these individuals. They found no cases of new COVID-19 that they could determine derived solely from these persistent positive cases. In a subset of 23 patients with persistent positive testing, 96% had developed neutralizing antibodies however it is still unclear whether antibodies for COVID-19 inter immunity.
Hope this helps with the confusion we are experiencing with repeat positive tests and our residents. Review the study at the link below and keep it in your COVID Toolkit for future reference should infection be questioned!